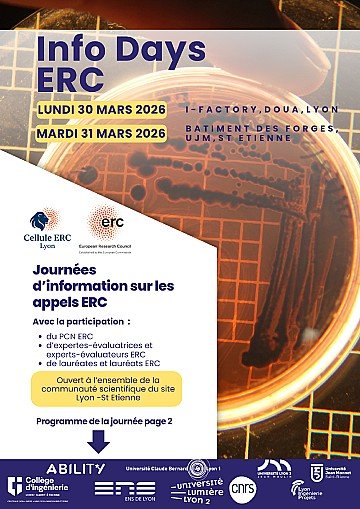
Press Release cover image

Vous travaillez sur des thématiques de recherche liées à la santé et vous souhaitez connaître les opportunités à l'Europe ? Ne manquez pas cette journée d’information sur les appels 2025 Horizon Europe, le mardi 18 mars sur le campus Rockefeller !
La matinée vous permettra de :
- Découvrir en avant-première les futurs appels à projets du Cluster Santé d’Horizon Europe.
- Échanger avec des experts et obtenir des conseils stratégiques.
- Bénéficier de retours d'expérience de lauréats de précédents appels.
Nous aurons notamment le plaisir d'accueillir un membre du Point de Contact National (PCN) Santé qui accompagne les porteurs de projets en fournissant des informations clés, un soutien à la mise en réseau et des recommandations stratégiques.
L’après-midi sera consacrée à des rendez-vous individuels avec le PCN ou la cellule Europe de votre choix. Attention, la réservation de ces rendez-vous est disponible via le formulaire d'inscription. Merci de bien valider votre participation à l'événement ainsi que votre créneau de rendez-vous.
Inscrivez-vous dès maintenant via ce lien : Lien d'inscription
Identifiez dès maintenant les appels susceptibles de vous intéresser !
Retrouvez en bas de cette page la liste des futurs appels Santé 2025, dont la publication officielle est prévue en mai (sous réserve de modifications). Ces appels sont classés par thématiques, nous vous invitons à les consulter en amont.
Mise en réseau et collaborations
Afin de favoriser les échanges et collaborations, la liste des participants sera diffusée après l’événement. Si vous ne souhaitez pas y figurer, merci d’indiquer votre préférence dans le formulaire d’inscription.
Télécharger le programme du 18 mars
Télécharger la liste des AAP 2025
Cet événement est organisé par l’Université Claude Bernard Lyon 1, le CNRS, l’INSERM, les Hospices civils de Lyon, Lyon ingénierie projets, l’ENS de Lyon, l’Université Lumière Lyon 2, l’Université Jean Moulin Lyon 3, dans le cadre du projet ASDESR ABILITY, financé par l’ANR au titre de France 2030 (ANR-22-ASDR-0001).